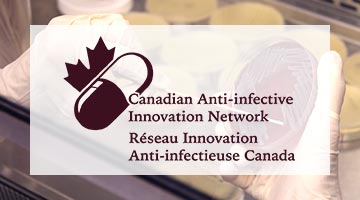

What is antimicrobial resistance?
Ever since the discovery of penicillin in 1929 and its use as a drug in the early 1940s, antibiotics have saved hundreds of millions of lives. These ‘miracle drugs’ cure life-threatening diseases such as pneumonia and sepsis, and enable doctors to perform high-risk medical procedures like hip and knee replacements and cancer chemotherapy. Without antibiotics, health practitioners would be unable to appropriately care for our most vulnerable populations such as the elderly, immune-compromised, and infants born preterm. However, the rapid emergence of drug-resistant pathogens threatens to reverse the progress that modern medicine has made.
Antimicrobial resistance (AMR) is a rapidly growing global problem. In 2016, U.K. government advisor Lord Jim O’Neill estimated that more than 700,000 people die each year from infections related to
drug resistance and that this number will exponentially rise to include an additional 50 million deaths by the year 2050 if no new solutions are found (O'Neill, 2016). Such solutions include the discovery of novel therapeutics (such as new antibiotics, antibiotic adjuvants, vaccines, and drugs that block resistance), the development of improved diagnostic strategies for the rapid identification of superbugs, and the more careful management of our existing drugs. Global innovators are addressing all of these strategies in an effort to combat the AMR crisis; however, its successful mitigation requires a disciplined, strategic, and interdisciplinary approach that emphasizes understanding, innovation, and collaboration throughout all levels of our global community.